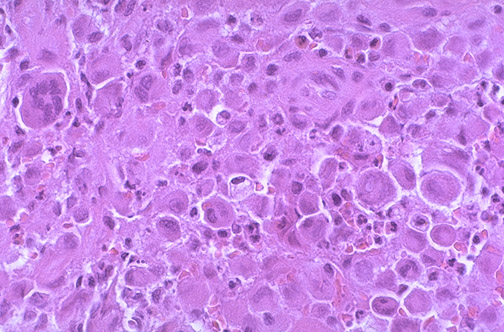

![]() | An eosinophilic granuloma of bone is one of the Langerhans cell histiocytoses. The characteristic cell is an oval to round macrophage, interspersed with inflammatory cells, including eosinophils. Eosinophilic granuloma is most common in children and young adults. This lesion forms within the marrow cavity and can expand to cause erosion of bone that produces pain or pathologic fracture. Some heal spontaneously by fibrosis, while other may require curretment. |
![]() |